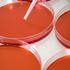

Rak dojke je najpogostejši rak žensk. Zatrdlina v dojki je najpogostejši znak. Drugi znaki, ki lahko
Žurnal24


Limfociti so odgovorni za imunost. Pri nenormalnem razvoju in rasti limfocitov se ti kopičijo v limf
Žurnal24


Levkemija je krvni rak. Pri večini levkemij se rakave bele krvničke širijo po telesu in povzročajo p
Žurnal24


Rak jeter je tretji najpogostejši vzrok umrljivosti zaradi raka. Skoraj vedno je smrtna bolezen, saj
Žurnal24

telo
Pri preprečevanju obolevnosti zaradi kožnega raka je zelo pomembno redno samoopazovanje. Maligni mel
Žurnal24




ženska, telo, boki, noge
Rak jajčnikov običajno prizadene ženske v meni, lahko pa se pojavi tudi pri mlajših ženskah. Obolenj
Žurnal24




